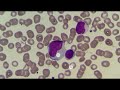

СКОЛЬКО 1 ТРИМЕСТР БЕРЕМЕННОСТИ ЭТО НЕДЕЛЬ
Первый триместр беременности длится примерно 12 недель. Этот период считается самым ранним и насыщенным развитием ребенка. В течение первого триместра будущая мама может испытывать различные симптомы, такие как утренняя тошнота, повышенная утомляемость и грудная нагруженность.
Первый триместр беременности. Часть 1
Скрининг первого триместра - Людмила Шупенюк и Волык Нелла
Первое УЗИ при беременности. Когда делать первое УЗИ и первую допплерометрию при беременности?
ПЕРВЫЙ ТРИМЕСТР - Сколько недель в первом триместре беременности и когда он заканчивается
10 Вещей, Которые Нельзя Делать в Первом Триместре Беременности
Скрининг 1-го триместра беременности